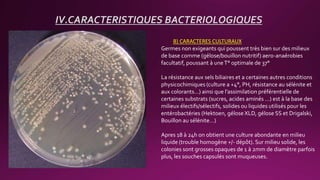
B) CARACTERES CULTURAUX
Germes non exigeants qui poussent très bien sur des milieux
de base comme (gélose/bouillon nutritif) aero-anaérobies
facultatif, poussant à uneT° optimale de 37°
La résistance aux sels biliaires et a certaines autres conditions
physicochimiques (culture a +4°, PH, résistance au sélénite et
aux colorants…) ainsi que l’assimilation préférentielle de
certaines substrats (sucres, acides aminés …) est à la base des
milieux électifs/sélectifs, solides ou liquides utilisés pour les
entérobactéries (Hektoen, gélose XLD, gélose SS et Drigalski,
Bouillon au sélénite…)
Apres 18 à 24h on obtient une culture abondante en milieu
liquide (trouble homogène +/- dépôt). Sur milieu solide, les
colonies sont grosses opaques de 1 à 2mm de diamètre parfois
plus, les souches capsulés sont muqueuses.
IV.CARACTERISTIQUES BACTERIOLOGIQUES
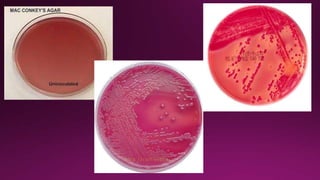
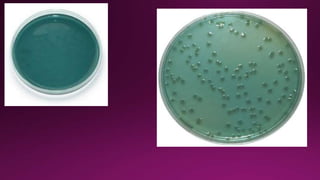
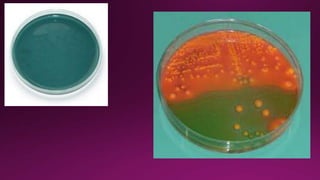
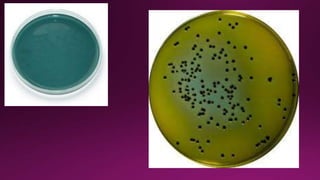
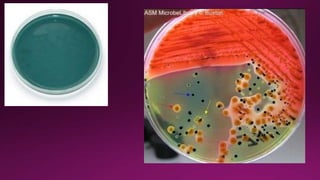

Ce document présente une étude détaillée sur les entérobactéries, y compris leur classification, leurs caractéristiques biochimiques et leur pouvoir pathogène. Les entérobactéries, telles qu'Escherichia coli, Salmonella et Shigella, sont responsables d'un large éventail d'infections, avec des mécanismes de virulence spécifiques et une résistance croissante aux antibiotiques. Il aborde également les méthodes de diagnostic et de prévention des infections causées par ces bactéries.